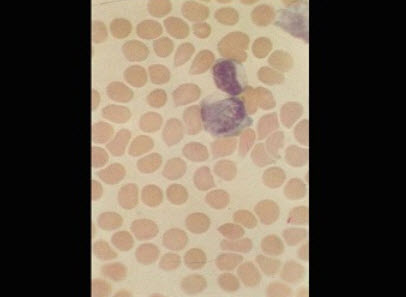

时间:2021-02-16 05:43:32


1、单项选择题 水痘的主要流行时间正确的是哪项()
A.春季1~2月
B.夏季6~7月
C.常年发生,但春冬季较多见
D.秋季9~10月
E.冬季11~12月
2、判断题 水痘皮疹呈向心性分布,躯干最多,其次为头面部及四肢近端。
3、单项选择题
以下关于水痘病原体的叙述哪项是正确的()
A.与单纯疱疹病毒同属于一个病毒科
B.存在于鼠类和家猪中
C.可在神经节潜伏感染,一定条件下可引起生殖器疱疹
D.是RNA病毒
E.可引起猩红热
4、问答题
刘×,女,15岁,汉族,学生,未婚,江西鹰潭市人,因发热、咽痛10天,全身皮疹7天入院。
9月24日起发热,体温最高41℃,伴畏寒,27日起出现皮疹,先躯干,后四肢,初红点,后突出皮面,融合成片。既往患“霉菌性肠炎”,长期服“丙戊酸钠、卡马西平”,50天前改为“治癫灵、吡拉西坦、丙戊酸钠”。体查:体温38.5℃,面潮红,有眼屑。全身大片红色斑丘疹,融合成片,压之褪色,无瘙痒。耳后、腋窝、腹股沟可见肿大淋巴结,咽红,扁桃体不大,心肺无异常,肝未及,脾肋下5cm。实验室检查:血常规:白细胞22.0×109/L,中性粒细胞0.45,淋巴细胞0.43,单核细胞0.07,异常淋巴细胞0.05,红细胞4×1012/L,血小板95×109/L
5、单项选择题
女,14岁,江西某市人,因发热7天,全身皮疹3天就诊,体检发现皮疹呈向心性分布,皮疹常呈椭圆形,3~5mm,周围有红晕,疱疹浅表易破。
下一步需什么治疗()
A.呼吸道隔离,对症处理
B.大剂量激素冲击
C.抗病毒治疗
D.抗生素治疗
E.免疫增强剂
6、单项选择题 传染性单核细胞增多症的治疗主要为()
A.抗菌
B.抗病毒
C.对症
D.激素
E.激素+抗病毒
7、问答题
刘×,男,32岁,因高热,咽痛14天,巩膜黄染5天,皮疹1天于2002年5月13日入院。
既往体健,否认肝炎、结核等病史。
体格检查:T39.2℃,P112次/分,BP100/60mmHg;急性病容,巩膜轻度黄染,躯干、四肢弥漫性鲜红色斑疹,间有少量出血点(如图);颌下、双颈侧及腋下可扪及多个豌豆大小淋巴结,有压痛;咽红,上腭散在针尖大小出血点,扁桃体Ⅱ度肿大,表面有白苔;心、肺无明显异常,肝肋下2cm,脾肋下1cm,有触痛。
实验室检查:血常规,WBC21.0×109/L,N0.18,L0.64,异型淋巴细胞0.18;尿胆红素(++),尿胆原(+);ALT131u/L,TBIL56.4mol/L;抗-HAVIgM(-),抗-HCV(-),抗-HBs(+),抗-HEV(-),抗EB-VCAIgM(+)
8、多项选择题 有关水痘临床特征,下述哪些是正确的()
A.水痘为自限性疾病,约10天左右自愈
B.免疫功能低下者易形成播散性水痘,病情轻
C.妊娠早期感染水痘可能引起胎儿畸形
D.孕妇若发生水痘后数天分娩,亦可发生新生儿水痘
E.重症水痘可发生水痘肺炎,水痘脑炎等并发症
9、名词解释 水痘
10、问答题
张×,男,17岁,因发热、皮疹4天于2003年12月14日入院。
患者12月10日无诱因出现皮疹、发热,体温不详,皮疹先见于躯干、头部,后延及全身。皮疹发展迅速,开始为红斑疹,数小时内变为丘疹,再形成疱疹,疱疹时感皮肤瘙痒,然后干结成痂。L2月14日又感咽痛。
体查:体温38℃,脉搏110次/分,呼吸20次/分,血压150/80mmHg,颜面、躯干见淡红色无血性皮疹,皮疹常呈椭圆形,3~5mm,周围有红晕,疱疹浅表易破。疱液初为透明,后混浊,继发感染可呈脓性,结痂时间延长并可留有瘢痕。(如图)淋巴结不大,咽充血,扁桃体Ⅱ度肿大,口腔处粘膜可见一浅表疱疹,破溃形成浅表性溃疡,有疼痛,心肺无异常,腹无压痛,肝脾未及。血常规:白细胞9.9×109/L,中性粒细胞0.46、淋巴细胞0.54,血色素157g/L。
11、单项选择题 带状疱疹是由以下哪种病原体引起的()
A.引起生殖器疱疹的病毒
B.原虫
C.细菌
D.立克次体
E.引起水痘的病毒
12、多项选择题 控制水痘传播的主要措施有哪些()
A.隔离水痘病人至皮疹完全结痂或出疹后7天
B.易感人群积极使用抗病毒药物
C.消毒水痘病人的分泌物污染物品
D.必要时向易感人群提供被动或主动免疫预防感染
E.带状疱疹病人也应该严密隔离
13、多项选择题 传染性单核细胞增多症时使用肾上腺皮质激素可明显减轻症状,其应用的适应证是()
A.伴咽部严重病变或水肿者
B.伴有神经系统并发症者
C.伴有心肌炎表现者
D.伴有溶血性贫血者
E.伴有血小板减少性紫癜
14、问答题
张×,男,17岁,因发热、皮疹4天于2003年12月14日入院。
患者12月10日无诱因出现皮疹、发热,体温不详,皮疹先见于躯干、头部,后延及全身。皮疹发展迅速,开始为红斑疹,数小时内变为丘疹,再形成疱疹,疱疹时感皮肤瘙痒,然后干结成痂。L2月14日又感咽痛。
体查:体温38℃,脉搏110次/分,呼吸20次/分,血压150/80mmHg,颜面、躯干见淡红色无血性皮疹,皮疹常呈椭圆形,3~5mm,周围有红晕,疱疹浅表易破。疱液初为透明,后混浊,继发感染可呈脓性,结痂时间延长并可留有瘢痕。(如图)淋巴结不大,咽充血,扁桃体Ⅱ度肿大,口腔处粘膜可见一浅表疱疹,破溃形成浅表性溃疡,有疼痛,心肺无异常,腹无压痛,肝脾未及。血常规:白细胞9.9×109/L,中性粒细胞0.46、淋巴细胞0.54,血色素157g/L。
15、多项选择题 以下关于水痘-带状疱疹病毒的叙述哪些是正确的()
A.与EB病毒同属于一个病毒科
B.可在表皮细胞中潜伏感染,一定条件下可引起带状疱疹
C.可引起猩红热
D.是DNA病毒
E.人类是惟一宿主
16、单项选择题 不伴咽喉炎而嗜异性抗体阴性的传染性单核细胞增多症几乎半数与何种病毒有关()
A.HAV
B.CMV
C.HBV
D.风疹病毒
E.腺病毒
17、填空题 一般水痘皮疹经过________、________、_________、___________各阶段。
18、单项选择题 对携带有EBV的B淋巴细胞起杀伤作用的细胞是() 91ExAm.org
A.浆细胞
B.巨噬细胞
C.CTL
D.中性粒细胞
E.NK细胞
19、问答题 如何鉴别正常人与传染性单核细胞增多症病人血清中的嗜异性抗体?
20、判断题 传染性单核细胞增多症是由EB病毒(EBV)所致的急性自限性传染病。
21、问答题
张×,男,17岁,学生,江西上饶人,因发热、皮疹4天于2000年12月14日入院。
患者12月10日无诱因出现皮疹、发热,体温不详,皮疹先躯干,后头面部及四肢颜色红,伴瘙痒。伴咳嗽、咳黄痰。L2月14日又感咽痛,发病前1个月曾服“卡马西平”。
体查:体温38℃,脉搏110次/分,呼吸20次/分,血压150/80mmHg,颜面、躯干见淡红色无血性皮疹,融合成片,出皮肤面表面。双手见压之不褪色,红色皮疹。双下肢散在芝麻大小皮疹,突起于表面,压之褪色。颈后、腋下、腹股沟可见1~3cm大小淋巴结质硬,无触痛,咽充血,扁桃体Ⅱ度肿大,心肺无异常,腹无压痛,肝脾未及。
血常规:白细胞39.9×109/L,中性粒细胞0.12、淋巴细胞0.10,异常淋巴细胞0.78,血色素147g/L。
22、单项选择题
图,以下关于水痘的典型皮疹的叙述哪项是正确的()

A.与带状疱疹的分布部位相同
B.弥漫性皮疹为主,疹间皮肤正常
C.愈后大多留有瘢痕
D.皮疹多见于四肢和颜面部
E.以疱疹最多见,分批出现
23、问答题
刘×,女,15岁,汉族,学生,未婚,江西鹰潭市人,因发热、咽痛10天,全身皮疹7天入院。
9月24日起发热,体温最高41℃,伴畏寒,27日起出现皮疹,先躯干,后四肢,初红点,后突出皮面,融合成片。既往患“霉菌性肠炎”,长期服“丙戊酸钠、卡马西平”,50天前改为“治癫灵、吡拉西坦、丙戊酸钠”。体查:体温38.5℃,面潮红,有眼屑。全身大片红色斑丘疹,融合成片,压之褪色,无瘙痒。耳后、腋窝、腹股沟可见肿大淋巴结,咽红,扁桃体不大,心肺无异常,肝未及,脾肋下5cm。实验室检查:血常规:白细胞22.0×109/L,中性粒细胞0.45,淋巴细胞0.43,单核细胞0.07,异常淋巴细胞0.05,红细胞4×1012/L,血小板95×109/L
24、多项选择题 下述哪些实验室检查有助于传染性单核细胞增多症的诊断()
A.血常规检查发现异常淋巴细胞增多10%
B.异凝集试验1:64阳性
C.尿常规发现蛋白尿
D.EBV抗体检查阳性
E.EBV-DNA检测阳性
25、多项选择题 下列哪些病原体可引起类传染性单核细胞增多症综合征()
A.CMV
B.HIV
C.李斯特菌属
D.刚地弓形虫
E.血吸虫
26、单项选择题 以下关于水痘的病后免疫的叙述哪项是不正确的()
A.只有1种血清型,因此病后免疫具有较好保护作用
B.病后免疫不能完全清除病毒,易于潜伏感染,仍可发生带状疱疹
C.大多病后免疫持久
D.目前已经有主动免疫疫苗提供
E.是原虫感染,无病后免疫
27、多项选择题 EBV感染常用的检测方法有()
A.原位杂交
B.嗜异性凝集试验
C.EBVDNA检测
D.EBV抗体检测
E.多聚酶链反应
28、单项选择题 水痘主要是通过以下哪一途径传播的()
A.血液传播
B.垂直传播
C.水痘疱疹液接触传播
D.经水传播
E.饮食传播
29、问答题
孙×,女,20岁,汉族,未婚,农民,宁都县会同乡人。因发热12天,咽痛6天于2000年3月14日入院。
3月2日无诱因发热,体温38~40℃,无明显畏寒、寒战。3月8日起咽痒,黄脓痰,入院查体:体温38℃,脉搏86次/分,呼吸20次/分,巩膜轻度黄染,双颌下、颈后、腋下,腹股沟见数个蚕豆大小淋巴结,质中偏硬,无压痛,界清,可以移动。无皮疹、咽充血,扁桃体不大,双肺呼吸音清,腹无压痛,肝肋下未及,脾肋下1cm。
血常规:白细胞22.5×109/L,中性粒细胞0.37,淋巴细胞0.57,异常淋巴细胞0.06,血色素157g/L,血小板258×109/L。
30、填空题 水痘皮疹分布特点为__________、___________、_________、_________、_________、_________。
31、单项选择题 以下关于水痘的临床表现的叙述哪项是正确的()
A.皮疹部位大多疼痛十分明显
B.皮疹分批发生,颜面部分布最多
C.多与带状疱疹同时发生
D.疱疹性皮疹和愈后留瘢痕是其特点
E.大多为自限性疾病
32、名词解释 Pawl-Bunnell嗜异性抗体
33、单项选择题 传染性单核细胞增多症的皮疹多见于第几病日()
A.7~14
B.4~6
C.1~2
D.3~4
E.7~9
34、填空题 重症水痘可能发生________、________、________和________等严重并发症。
35、问答题
张×,男,17岁,因发热、皮疹4天于2003年12月14日入院。
患者12月10日无诱因出现皮疹、发热,体温不详,皮疹先见于躯干、头部,后延及全身。皮疹发展迅速,开始为红斑疹,数小时内变为丘疹,再形成疱疹,疱疹时感皮肤瘙痒,然后干结成痂。L2月14日又感咽痛。
体查:体温38℃,脉搏110次/分,呼吸20次/分,血压150/80mmHg,颜面、躯干见淡红色无血性皮疹,皮疹常呈椭圆形,3~5mm,周围有红晕,疱疹浅表易破。疱液初为透明,后混浊,继发感染可呈脓性,结痂时间延长并可留有瘢痕。(如图)淋巴结不大,咽充血,扁桃体Ⅱ度肿大,口腔处粘膜可见一浅表疱疹,破溃形成浅表性溃疡,有疼痛,心肺无异常,腹无压痛,肝脾未及。血常规:白细胞9.9×109/L,中性粒细胞0.46、淋巴细胞0.54,血色素157g/L。
治疗原则及主要注意事项。

36、问答题
刘×,男,32岁,因高热,咽痛14天,巩膜黄染5天,皮疹1天于2002年5月13日入院。
既往体健,否认肝炎、结核等病史。
体格检查:T39.2℃,P112次/分,BP100/60mmHg;急性病容,巩膜轻度黄染,躯干、四肢弥漫性鲜红色斑疹,间有少量出血点(如图);颌下、双颈侧及腋下可扪及多个豌豆大小淋巴结,有压痛;咽红,上腭散在针尖大小出血点,扁桃体Ⅱ度肿大,表面有白苔;心、肺无明显异常,肝肋下2cm,脾肋下1cm,有触痛。
实验室检查:血常规,WBC21.0×109/L,N0.18,L0.64,异型淋巴细胞0.18;尿胆红素(++),尿胆原(+);ALT131u/L,TBIL56.4mol/L;抗-HAVIgM(-),抗-HCV(-),抗-HBs(+),抗-HEV(-),抗EB-VCAIgM(+)
该病人需进一步完善哪些检查?

37、问答题
刘×,女,15岁,汉族,学生,未婚,江西鹰潭市人,因发热、咽痛10天,全身皮疹7天入院。
9月24日起发热,体温最高41℃,伴畏寒,27日起出现皮疹,先躯干,后四肢,初红点,后突出皮面,融合成片。既往患“霉菌性肠炎”,长期服“丙戊酸钠、卡马西平”,50天前改为“治癫灵、吡拉西坦、丙戊酸钠”。体查:体温38.5℃,面潮红,有眼屑。全身大片红色斑丘疹,融合成片,压之褪色,无瘙痒。耳后、腋窝、腹股沟可见肿大淋巴结,咽红,扁桃体不大,心肺无异常,肝未及,脾肋下5cm。实验室检查:血常规:白细胞22.0×109/L,中性粒细胞0.45,淋巴细胞0.43,单核细胞0.07,异常淋巴细胞0.05,红细胞4×1012/L,血小板95×109/L
38、填空题 嗜异性抗体属_________型抗体,是EBV感染后非特异性活化_______细胞产生的抗体。
39、多项选择题 传染性单核细胞增多症的可能并发症有()
A.自身免疫性溶血性贫血
B.血小板减少性紫癜
C.脾破裂
D.格林-巴利综合征
E.脑膜脑炎
40、单项选择题 以下关于典型水痘治疗原则的叙述哪项是正确的()
A.积极使用皮质激素减少免疫损伤
B.急性期应卧床休息,注意水、电解质和各种营养素的供给
C.积极镇痛和使用抗生素预防合并感染
D.与带状疱疹的处理原则相同
E.抗病毒药物的使用最为重要
41、单项选择题 以下关于水痘的病后免疫的叙述哪项是正确的()
A.病后免疫不强,易反复感染
B.无病后免疫,病毒易于潜伏感染
C.病后免疫持久,但仍可发生带状疱疹
D.有多种血清型,因此病后免疫并无多大保护作用
E.病后免疫持久,病毒完全清除
42、多项选择题 水痘病原体可以通过以下哪些途径传播()
A.空气飞沫传播
B.输血传播
C.皮疹液传播
D.垂直传播
E.饮食传播
43、单项选择题
女,25岁,江西上饶人,因发热、咽痛一周就诊。查体见患者咽部有溃疡及伪膜形成,可见出血点。颈淋巴结肿大,白细胞总数增多,达30×10/L。可见异型淋巴细胞。
治疗不应首选以下哪种药物()
A.青霉素G
B.红霉素
C.灭滴灵
D.氨苄青霉素
E.氯林可霉素
44、填空题 水痘的主要传染源是_________,其病原体可以长期潜伏在__________中,在某些诱因的作用下引起另外一种常见疾病的发生。
45、问答题 简述水痘的皮疹形态和发病过程。
46、填空题 导致单核细胞增多症的病毒包括________、_________、_________、__________、________。
47、单项选择题 V形柴油机在拆装活塞时,最容易出现的损伤是()。
A.活塞环断裂
B.连杆大端碰伤缸套
C.活塞卡在缸套内
D.连杆大端碰伤曲轴
48、多项选择题 关于水痘的流行病学特点哪些是正确的()
A.传染性强,婴幼儿易感
B.春冬季节常见
C.主要传染源是水痘病人
D.病后免疫力大多不强
E.主要通过血液传播
49、问答题
刘×,男,32岁,因高热,咽痛14天,巩膜黄染5天,皮疹1天于2002年5月13日入院。
既往体健,否认肝炎、结核等病史。
体格检查:T39.2℃,P112次/分,BP100/60mmHg;急性病容,巩膜轻度黄染,躯干、四肢弥漫性鲜红色斑疹,间有少量出血点(如图);颌下、双颈侧及腋下可扪及多个豌豆大小淋巴结,有压痛;咽红,上腭散在针尖大小出血点,扁桃体Ⅱ度肿大,表面有白苔;心、肺无明显异常,肝肋下2cm,脾肋下1cm,有触痛。
实验室检查:血常规,WBC21.0×109/L,N0.18,L0.64,异型淋巴细胞0.18;尿胆红素(++),尿胆原(+);ALT131u/L,TBIL56.4mol/L;抗-HAVIgM(-),抗-HCV(-),抗-HBs(+),抗-HEV(-),抗EB-VCAIgM(+)
50、单项选择题 关于水痘的流行病学特点哪项是正确的()
A.传染性强,婴幼儿易感
B.病后免疫力大多不强
C.带状疱疹病人是最主要的传染源
D.主要通过血液传播
E.夏秋季节常见
51、单项选择题
女,14岁,江西某市人,因发热7天,全身皮疹3天就诊,体检发现皮疹呈向心性分布,皮疹常呈椭圆形,3~5mm,周围有红晕,疱疹浅表易破。
进一步需做以下哪项检查()
A.病毒分离
B.嗜异性凝集试验
C.病人血清抗麻疹IgM
D.以EHFV抗原片,检测患者双份血清
E.X线胸片
52、单项选择题
女,25岁,江西上饶人,因发热、咽痛一周就诊。查体见患者咽部有溃疡及伪膜形成,可见出血点。颈淋巴结肿大,白细胞总数增多,达30×10/L。可见异型淋巴细胞。
应做哪项检查确诊()
A.咽拭子培养
B.嗜异性凝集试验
C.X线胸片
D.血凝抑制试验
E.补体结合试验
53、填空题 水痘与________是由同一种病毒,即________病毒引起的不同表现的疾病。
54、问答题
张×,男,17岁,学生,江西上饶人,因发热、皮疹4天于2000年12月14日入院。
患者12月10日无诱因出现皮疹、发热,体温不详,皮疹先躯干,后头面部及四肢颜色红,伴瘙痒。伴咳嗽、咳黄痰。L2月14日又感咽痛,发病前1个月曾服“卡马西平”。
体查:体温38℃,脉搏110次/分,呼吸20次/分,血压150/80mmHg,颜面、躯干见淡红色无血性皮疹,融合成片,出皮肤面表面。双手见压之不褪色,红色皮疹。双下肢散在芝麻大小皮疹,突起于表面,压之褪色。颈后、腋下、腹股沟可见1~3cm大小淋巴结质硬,无触痛,咽充血,扁桃体Ⅱ度肿大,心肺无异常,腹无压痛,肝脾未及。
血常规:白细胞39.9×109/L,中性粒细胞0.12、淋巴细胞0.10,异常淋巴细胞0.78,血色素147g/L。
55、单项选择题 水痘的主要传染源是以下哪项()
A.麻疹病人
B.单纯疱疹病人
C.带状疱疹病人
D.水痘病人
E.猩红热病人
56、单项选择题 血液中异型淋巴细胞超过多少对传染性单核细胞增多症具有诊断价值()
A.10%
B.0.2%
C.1%
D.5%
E.50%
57、单项选择题 关于水痘病原体潜伏性感染的叙述哪项是正确的()
A.多在成人后再次发病,表现为带状疱疹
B.病原体潜伏于表皮细胞中
C.大多见于隐性感染的病人
D.是水痘未愈的表现
E.机体产生抗体后可以清除潜伏感染的病原体
58、单项选择题
女,14岁,江西某市人,因发热7天,全身皮疹3天就诊,体检发现皮疹呈向心性分布,皮疹常呈椭圆形,3~5mm,周围有红晕,疱疹浅表易破。
考虑诊断()
A.水痘
B.传染性单核细胞增多症
C.麻疹
D.风疹
E.流行性出血热
59、配伍题 HAV()水痘病毒()HBV()HIV()汉坦病毒()
A.生活能力较弱,不耐高温,不能在痂皮中存活,易被消毒剂灭活。但能在疱疹液中-65℃下存活8年。
B.在体外抵抗力较强,在-20℃条件下保存数年,其传染性不变,能耐受56℃30分钟的温度及pH3的酸度;加热煮沸(100℃)5分钟或干热160℃20分钟,紫外线照射1小时,氯1mg/L30分钟或甲醛(1:4000)37℃72小时均可使之灭活
C.在体外抵抗力很强,紫外线照射,加热60℃4小时及一般浓度的化学消毒剂(如苯酚,硫柳汞等)均不能使之灭活,在干燥或冰冻环境下能生存数月到数年,加热60℃持续10小时,煮沸(100℃)20分钟,高压蒸汽122℃10分钟或过氧乙酸(0.5%)7.5分钟以上则可以灭活
D.对外界抵抗力较弱,加热56℃30分钟和一般消毒剂如0.5%次氯酸钠,5%甲醛、70%乙醇2%戊二醛等均可灭活,但对紫外线不敏感
E.对脂溶剂很敏感,易被紫外线及γ射线灭活,一般消毒剂(碘酒、酒精、福尔马林等)均可将病毒杀灭
60、问答题 简述水痘、带状疱疹的治疗原则。
61、判断题 EBV有四种抗原成分,即病毒衣壳抗原(VcA)、膜抗原(MA)、补体结合抗原(可溶性抗原S)和核抗原(EBNA)。
62、判断题 水痘病毒生活能力较弱,不耐高温,不能在痂皮中存活,易被消毒剂灭活。但能在疱疹液中-65℃下存活8年。
63、单项选择题
如图,传染性单核细胞增多症病人血液中异型淋巴细胞增多,它属于哪一种细胞()
A.TH1细胞
B.TH2细胞
C.TSB
D.CTL
E.淋巴细胞
64、填空题 重症患者如______________、____________、___________、___________时,应用短疗程肾上腺皮质激素可明显减轻症状。
65、填空题 带状疱疹多限于___________,皮损很少超过____________。
66、单项选择题 B淋巴细胞表面有以下哪种EBV受体()
A.CD19
B.CD21
C.CD24
D.CD40
E.CD81
67、单项选择题 传染性单核细胞增多症测不出嗜异性抗体的比例为()
A.20%~30%
B.10%~15%
C.15%~25%
D.<5%
E.5%~10%
68、多项选择题 与EBV感染有关的疾病有()
A.器官移植病人的淋巴增生性疾病
B.Burkitt淋巴瘤
C.霍奇金病
D.传染性单核细胞增多症
E.鼻咽癌
69、填空题 传染性单核细胞增多症主要经______传播,给易感人群输全血或输入含有________细胞的血液可导致症状性原发感染。
70、单项选择题
女,25岁,江西上饶人,因发热、咽痛一周就诊。查体见患者咽部有溃疡及伪膜形成,可见出血点。颈淋巴结肿大,白细胞总数增多,达30×109/L。可见异型淋巴细胞。
考虑诊断什么病()
A.急性扁桃体炎
B.白喉
C.传染性单核细胞增多症
D.流感
E.真菌感染
71、多项选择题 传染性单核细胞增多症主要临床表现包括()
A.淋巴结肿大
B.咽痛
C.肝脾大
D.胸骨压痛
E.发热
72、问答题
张×,男,17岁,学生,江西上饶人,因发热、皮疹4天于2000年12月14日入院。
患者12月10日无诱因出现皮疹、发热,体温不详,皮疹先躯干,后头面部及四肢颜色红,伴瘙痒。伴咳嗽、咳黄痰。L2月14日又感咽痛,发病前1个月曾服“卡马西平”。
体查:体温38℃,脉搏110次/分,呼吸20次/分,血压150/80mmHg,颜面、躯干见淡红色无血性皮疹,融合成片,出皮肤面表面。双手见压之不褪色,红色皮疹。双下肢散在芝麻大小皮疹,突起于表面,压之褪色。颈后、腋下、腹股沟可见1~3cm大小淋巴结质硬,无触痛,咽充血,扁桃体Ⅱ度肿大,心肺无异常,腹无压痛,肝脾未及。
血常规:白细胞39.9×109/L,中性粒细胞0.12、淋巴细胞0.10,异常淋巴细胞0.78,血色素147g/L。
73、配伍题 流行性斑疹伤寒()传染性单核细胞增多症()登革热()流行性腮腺炎()猩红热()
A.EB病毒
B.腮腺炎病毒
C.普氏立克次体
D.β溶血性链球菌
E.登革热病毒
74、单项选择题 EBV入口腔后可能先在哪一淋巴组织内增殖,而后入血液循环产生病毒血症()
A.咽部
B.肺部
C.胃
D.小肠
E.结肠回盲部
75、问答题 水痘和带状疱疹发病学上有什么关系?
76、问答题
孙×,女,20岁,汉族,未婚,农民,宁都县会同乡人。因发热12天,咽痛6天于2000年3月14日入院。
3月2日无诱因发热,体温38~40℃,无明显畏寒、寒战。3月8日起咽痒,黄脓痰,入院查体:体温38℃,脉搏86次/分,呼吸20次/分,巩膜轻度黄染,双颌下、颈后、腋下,腹股沟见数个蚕豆大小淋巴结,质中偏硬,无压痛,界清,可以移动。无皮疹、咽充血,扁桃体不大,双肺呼吸音清,腹无压痛,肝肋下未及,脾肋下1cm。
血常规:白细胞22.5×109/L,中性粒细胞0.37,淋巴细胞0.57,异常淋巴细胞0.06,血色素157g/L,血小板258×109/L。
77、填空题 重症水痘可发生__________、_____________、_____________等。
78、单项选择题 传染性单核细胞增多症病人浅表淋巴结肿大以哪一区最常见()
A.锁骨上
B.滑车上
C.颈后三角
D.腋下
E.腹股沟
79、单项选择题
女,14岁,江西某市人,因发热7天,全身皮疹3天就诊,体检发现皮疹呈向心性分布,皮疹常呈椭圆形,3~5mm,周围有红晕,疱疹浅表易破。
考虑诊断()
A.水痘
B.传染性单核细胞增多症
C.麻疹
D.风疹
E.流行性出血热
80、单项选择题 带状疱疹最常见于以下哪个部位()
A.三叉神经分布区域
B.脊神经胸段分布区域
C.面神经分布区域
D.腹部
E.四肢
81、多项选择题 传染性单核细胞增多症临床表现多样化,主要的临床表现有()
A.不规则发热、伴畏寒,热程数日至数周不等
B.浅表淋巴结肿大、压痛
C.咽部充血水肿、疼痛
D.肝脾肿大
E.可出现皮肤斑疹、丘疹,皮肤出血点或猩红热样皮疹
82、单项选择题 传染性单核细胞增多症的典型症状是()
A.发热、腹痛、淋巴结肿大
B.发热、黄疸、肝脾大
C.发热、咽痛、淋巴结肿大
D.发热、咽痛、腹痛
E.发热、皮疹、肝脾大
83、单项选择题 以下关于带状疱疹的叙述哪项是正确的()
A.最常见的发生部位是脊神经胸段分布区域
B.发病的主要诱因是机体免疫功能亢进
C.病人常有婴幼儿时期麻疹病史
D.大多为感觉神经分布的区域,病变多对称出现
E.是一种细菌感染引起的疾病
84、问答题
孙×,女,20岁,汉族,未婚,农民,宁都县会同乡人。因发热12天,咽痛6天于2000年3月14日入院。
3月2日无诱因发热,体温38~40℃,无明显畏寒、寒战。3月8日起咽痒,黄脓痰,入院查体:体温38℃,脉搏86次/分,呼吸20次/分,巩膜轻度黄染,双颌下、颈后、腋下,腹股沟见数个蚕豆大小淋巴结,质中偏硬,无压痛,界清,可以移动。无皮疹、咽充血,扁桃体不大,双肺呼吸音清,腹无压痛,肝肋下未及,脾肋下1cm。
血常规:白细胞22.5×109/L,中性粒细胞0.37,淋巴细胞0.57,异常淋巴细胞0.06,血色素157g/L,血小板258×109/L。
85、单项选择题 大多数伴有咽喉炎而嗜异性抗体阴性的传染性单核细胞增多症是由以下哪种病原体所引起()
A.MV
B.肝炎病毒
C.EBV
D.腺病毒
E.弓形虫
86、单项选择题 水痘与以下何种疾病是由相同的病原体引起的()
A.单纯疱疹
B.麻疹
C.带状疱疹
D.风疹
E.猩红热
87、单项选择题 传染性单核细胞增多症继发链球菌感染时,忌用()
A.庆大霉素
B.红霉素
C.丁胺卡那霉素
D.氨苄西林
E.林可霉素
88、单项选择题 传染性单核细胞增多症病人的肝、脾、肾、骨髓、中枢神经系统均可受累,主要病理表现为何种细胞浸润()
A.淋巴细胞
B.单核吞噬细胞系统
C.中性粒细胞
D.异常的多形性淋巴细胞
E.嗜酸性粒细胞